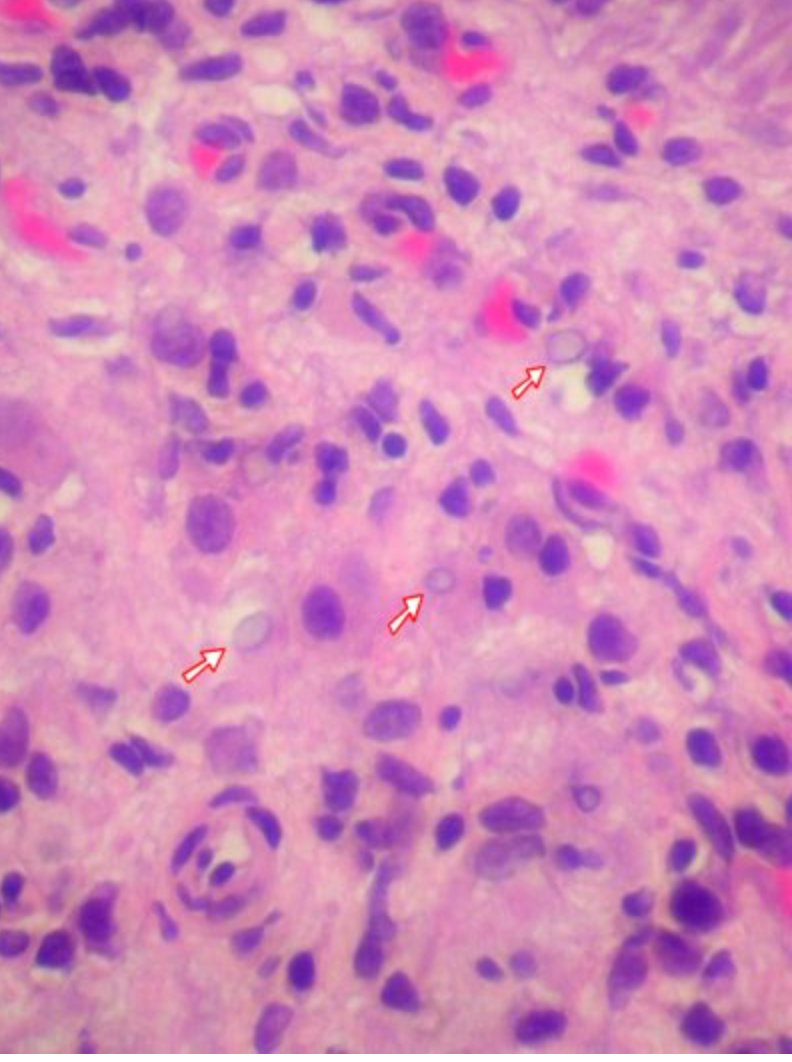

EBV least associated with:
* Hodgkin lymphoma
* **Oral cancer in a young person**
* Endemic nasopharyngeal carcinoma - True
* Endemic Burkitts
* X
https://www.ncbi.nlm.nih.gov/pmc/articles/PMC5554094/
Epstein-Barr Virus in the Pathogenesis of Oral Cancers
Joseph T. Guidry, Christine E. Birdwell, and Rona S. Scott\*
Author information Copyright and License information Disclaimer
The publisher's final edited version of this article is available at Oral Dis
See other articles in PMC that cite the published article.
Go to:
Abstract
Epstein-Barr virus (EBV) is a ubiquitous gammaherpesvirus that establishes a lifelong persistent infection in the oral cavity and is intermittently shed in the saliva. EBV exhibits a biphasic life cycle, supported by its dual tropism for B lymphocytes and epithelial cells, which allows the virus to be transmitted within oral lymphoid tissues. While infection is often benign, EBV is associated with a number of lymphomas and carcinomas that arise in the oral cavity and at other anatomical sites. Incomplete association of EBV in cancer has questioned if EBV is merely a passenger or a driver of the tumorigenic process. However, the ability of EBV to immortalize B cells and its prevalence in a subset of cancers has implicated EBV as a carcinogenic cofactor in cellular contexts where the viral lifecycle is altered. In many cases, EBV likely acts as an agent of tumor progression rather than tumor initiation, conferring malignant phenotypes observed in EBV-positive cancers. Given that the oral cavity serves as the main site of EBV residence and transmission, here we review the prevalence of EBV in oral malignancies and the mechanisms by which EBV acts as an agent of tumor progression.
Keywords: Epstein-Barr virus (EBV), lymphoma, carcinoma, tumor
Go to:
EBV life cycle in the oral cavity
Epstein-Barr virus is a gammaherpesvirus that establishes life-long persistent infections in the oral cavity in the majority of adults worldwide. Infection typically begins in early childhood, with 50% of children infected by the age of five (Porter et al., 1969). Acquisition of the virus continues through adulthood with greater than 90% of adults becoming infected (Cohen et al., 2011). Early EBV infections are generally mild or asymptomatic; but primary infection in adolescence carries an increased risk for developing infectious mononucleosis (IM), a self-limited lymphoproliferative disease with a clinical triad of fever, pharyngitis, and swollen lymph nodes (Henle et al., 1968, Niederman et al., 1976). The symptoms of IM are primarily due to a massive T cell response to the EBV-infected B cell blasts with replication of the virus in the oropharynx (Murray et al., 1992, Schendel et al., 1992). Other viral and parasitic pathogens can cause IM-like symptoms, but IM caused by EBV is typically associated with a heterophile-positive antibody response that is the basis for the Monospot clinical mononucleosis test. IM patients have high viral loads in blood and saliva for 6 months after convalescence (Fafi-Kremer et al., 2005). Following primary infection, EBV establishes a lifelong infection, with periodic, asymptomatic EBV shedding.
The oral cavity is a primary site for transmission and persistence of EBV. EBV disseminates to other anatomical sites, and is found in blood circulating B cells in healthy carriers at a frequency of 1 to 50 in 106 B lymphocytes (Khan et al., 1996). EBV is periodically shed in the saliva throughout the lifetime of infected individuals and can be transmitted to naïve individuals (Ling et al., 2003, Yao et al., 1985). Lifelong carriage of EBV is achieved by the biphasic nature of the viral life cycle. Transmission via the oral cavity targets epithelial cells and naïve B lymphocytes for infection. Lymphoid rich regions in the oral cavity such as tonsils and adenoids that constitute Waldeyer’s ring juxtapose epithelial and B lymphocytes for efficient entry and egress of the virus (Hadinoto et al., 2009, Niederman et al., 1976). Indeed, EBV is frequently detected in adenoids and tonsils, but not the hard palate (Berger et al., 2007, Jiang et al., 2015). Epithelial cells support the amplification of the virus shed in saliva, while B lymphocytes, specifically memory B cells, are the primary reservoir for long term persistence of EBV (Babcock et al., 1998, Hadinoto et al., 2009, Jiang et al., 2006).
The EBV virion consists of an enveloped capsid that carries a linear, double-stranded DNA genome approximately 170 kilobase pairs in length. Entry into naïve B lymphocytes and epithelial cells is mediated by engagement of viral glycoproteins on the viral envelope with cellular receptors on the cell’s plasma membrane (reviewed in (Chesnokova et al., 2015)). The virus enters cells by either endocytosis in B lymphocytes or direct fusion of the viral envelope with the plasma membrane of epithelial cells. Inside the virion, the linear EBV genome carries few epigenetic marks being mostly devoid of DNA methylation or histones (Fernandez et al., 2009, Szyf et al., 1985). Following entry, the virus delivers its linear genome to the nucleus where the genome undergoes a circularization event through recombination of terminal repeats present at the ends of the linear DNA (Lindahl et al., 1976). Each circularization event results in a fused terminal repeat fragment that has a unique number of repeats, and is used as a marker for viral clonality (Raab-Traub & Flynn, 1986). Furthermore, the EBV genome in cells is replicated and maintained as an extrachromosomal episome. The EBV genome also rapidly associates with nucleosomes and the viral DNA is methylated having a similar chromatin structure as the host genome (Kalla et al., 2010). DNA methylation and histone modifications are epigenetic marks that regulate gene expression. Depending on the cellular context, EBV establishes various viral gene expression states that are integral to completion of the viral lifecycle.
EBV infection of B cells supports the latent phase of the viral life cycle and long term viral persistence (Qu & Rowe, 1992, Rooney et al., 1989, Tierney et al., 1994). Memory B cells are the lifelong reservoir for EBV. EBV reaches memory B cells by direct infection or by navigating short-lived B cells through their differentiation program into long-lived memory B cells (Kurth et al., 2003, Thorley-Lawson & Gross, 2004). Several EBV latency programs, characterized by a set of increasingly restricted viral gene expression patterns, have been observed at different points in the B cell differentiation program (Table 1). The EBV latency programs result from silencing of viral gene expression to avoid elimination by cytotoxic T cells as an immune evasion strategy required for viral persistence in the B cell compartment (Murray et al., 1992, Schendel et al., 1992). Epigenetic modifications, such as DNA methylation and histone modifications, on viral promoters regulate various viral gene expression states. In naïve B cells, six Epstein-Barr virus nuclear antigens (EBNA) 1, 2, 3A, 3B, 3C, and LP, and three latent membrane proteins (LMP) 1, 2A, and 2B are expressed. Known as latency III or the growth program, these viral factors promote B cell growth and are required for in vitro B cell immortalization (Reviewed in (Kang & Kieff, 2015)). The EBNA proteins are involved in transcriptional regulation while LMP1 mimics CD40 signaling and LMP2 mimics B cell receptor signaling, together providing signals necessary for B cell activation, proliferation, and cell survival (Reviewed in (Kang & Kieff, 2015)). In germinal center B cells, four latency proteins are expressed: EBNA1, LMP1, LMP2A, and LMP2B (known as Latency II or the default program). In dividing memory B cells, the latency I program is limited to expression of EBNA1, which is required for the maintenance of the viral episome during cell division (Yates et al., 1984), and LMP2A (Babcock et al., 2000). Latency 0 is the absence of all viral gene expression and has been reported in non-dividing memory B cells (Decker et al., 1996, Ruf & Sample, 1999). In addition, EBV has non-coding RNAs that are expressed in the latency programs that include the EBV-encoded RNAs (EBERs), BamH1 fragment A rightward transcripts (BARTs), and viral microRNAs (Qu & Rowe, 1992, Tierney et al., 1994). Rescue from latency and induction of the productive phase of the viral life cycle (termed viral reactivation) occurs upon terminal differentiation of memory B cells into plasma cells, which is induced upon antigen stimulation of the cognate B cell receptor (Crawford & Ando, 1986, Laichalk & Thorley-Lawson, 2005). Virus released from the B cell can then infect epithelial cells where the virus is amplified for cell-to-cell spread or infection of a new host. Epithelial differentiation also regulates the viral lifecycle, with viral replication occurring in the upper differentiated layers (Greenspan et al., 1985, Sixbey et al., 1984, Tugizov et al., 2003). Epithelial cells may also harbor latent EBV infection, but the nature of EBV epithelial latency is less understood than in B cells (Reusch et al., 2015).
Table 1
EBV gene expression programs
EBV Gene Expression ProgramCell compartmentPhenotypeEBV Genes ExpressedAssociated Diseases
Latency IIINaïve B cellsEBV-induced B cell growth and survival
B cell immortalizationEBNA1, 2, 3A,3B, 3C and EBNA LP
LMP1, 2A, 2B
EBV BART
EBV miRNAs
EBER 1 and 2DLBCL, PTLD, IM
Latency IIGerminal Center B cellsB cell survivalEBNA1
LMP1, 2A, 2B
EBV BARTs
EBV miRNAs
EBER 1 and 2DLBCL, HL, NPC and GC
Latency IDividing Memory B cellsEBV episome maintenanceEBNA1
EBV BARTs
EBV miRNAs
EBER 1 and 2BL
Latency 0Non-dividing memory B cellsQuiescent stateNone
LyticPlasma B cells, Epithelial CellsViral replicationAll viral genes in an ordered cascade of viral gene expressionOHL
BART: BamH1 fragment A rightward transcript; BL: Burkitt’s lymphoma; DLBCL: Diffuse large B cell lymphoma; EBER: EBV-encoded RNA; EBNA: EBV nuclear antigen; GC: Gastric carcinoma; HL: Hodgkin’s lymphoma; IM: Infectious mononucleosis; LMP: Latent membrane protein; miRNA: microRNA; NPC: Nasopharyngeal carcinoma; OHL: Oral hairy leukoplakia; PTLD: Post-transplant lymphoproliferative disease
Go to:
EBV in the tumor context
EBV infections typically have no pathogenic consequences despite long term carriage of the virus. However, in some cases, EBV has been associated with a number of lymphoid and epithelial malignancies arising in the oral cavity and at other anatomical sites. The viral oncogenic potential is demonstrated by the ability of EBV-infected B lymphocytes to proliferate indefinitely as immortalized lymphoblastoid cell lines in vitro (Gerper et al., 1969, Henle et al., 1967). EBV was originally discovered in Burkitt’s lymphoma (BL), and EBV’s association with malignancies has expanded to include associations with Hodgkin’s lymphoma, natural killer/T cell lymphoma, nasopharyngeal carcinoma (NPC), gastric carcinoma, and oropharyngeal squamous cell carcinoma (OSCC) (Burke et al., 1990, Epstein et al., 1964, Henle & Henle, 1970, Jiang et al., 2012, Levine et al., 1971, Tao et al., 2002). As a persistent infection, EBV is tightly controlled by cell mediated innate and adaptive responses to prevent disease. In cases of immunosuppression, such as in transplant recipients or those living with acquired immunodeficiency syndrome (AIDS), there is an increased risk for developing an EBV-associated malignancy that includes post-transplant lymphoproliferative disease, oral plasmablastic lymphoma, primary effusion lymphoma coinfected with Kaposi’s sarcoma herpesvirus, primary central nervous system lymphoma, smooth muscle tumors, and oral hairy leukoplakia (OHL).
The mechanisms governing how EBV contributes to the tumorigenic process likely differ in each of its associated malignancies, but some common features are noted. In all EBV-associated malignancies, EBV is in a latent state. Viral latency allows for sustained expression of viral oncogenes while avoiding immune detection and cytopathic effects from the replicative phase of the viral lifecycle. Yet, high viral loads have also been correlated with tumor development as individuals with IM have 4-fold greater risk of developing Hodgkin’s lymphoma (Bernard et al., 1987, Carter et al., 1977, Connelly & Christine, 1974, Gutensohn & Cole, 1981, Hjalgrim et al., 2000, Kvale et al., 1979, Levine et al., 1998, Munoz et al., 1978, Rosdahl et al., 1973, Serraino et al., 1991). In addition, high EBV antibody titers have been detected in patients with BL, Hodgkin’s lymphoma, and NPC and precede tumor onset by a short period of only a few years (de-The, 1982, Levine et al., 1971, Mueller et al., 1989, Ji et al., 2007). As such, monitoring EBV antibody titers is used for the clinical detection of NPC (Lee et al., 1997, Zhong et al., 2006). The reasons behind such increased viral titers are unknown, but aberrant viral reactivation would increase the virus pool and the likelihood of infecting existing pre-neoplastic cells.
Confounding EBV’s role in cancer is an incomplete association of the virus in cancers of similar histogenetic phenotypes. However, EBV infection can also result in epigenetic reprogramming of lymphoid and epithelial cells (Birdwell et al., 2014, Hansen et al., 2014, Saha et al., 2015, Vockerodt et al., 2008). Epigenetic changes are defined as heritable changes in gene expression that do not result from DNA mutations. EBV-associated malignancies display altered DNA methylation states from EBV-negative tissues (Cancer Genome Atlas Research, 2014, Chang et al., 2006, Dai et al., 2015, Hansen et al., 2014). Viral factors have been shown to manipulate the host epigenetic machinery affecting the host epigenome as well, suggesting that EBV-induced epigenetic alterations can contribute to tumor progression in the absence of the virus or viral gene expression in a “hit-and-run” manner (Birdwell et al., 2014, Hino et al., 2009, Paschos et al., 2012, Skalska et al., 2010, Tsai et al., 2002). EBV also participates as co-factor that likely replaces the need for additional genetic and epigenetic alterations during cancer progression. The oral cavity where EBV is routinely shed is a key site to address some questions about EBV-associated malignancies. The sections that follow review the incidence of EBV-associated malignancies in the oral cavity and how EBV contributes to tumor progression of oral cancers.
Go to:
EBV and Oral Lymphoproliferative Diseases
In general, the occurrence of lymphomas in the oral cavity is rare accounting for less than 5% of all lymphoma (Silva et al., 2016). However, oral lymphomas are the third most frequent oral cancers following OSCC and salivary gland carcinomas (Silva et al., 2016). Hodgkin’s lymphoma, which is EBV-associated in approximately 50% of tumors, rarely presents in the oral cavity with only a handful of reported cases that involved the tongue, palate and tonsil (Darling et al., 2012). Diffuse large B-cell (DLBCL) and Burkitt’s lymphomas are the most common EBV-associated non-Hodgkin’s lymphomas that occur in the oral cavity (Silva et al., 2016). Despite a continual presence of EBV in the oral cavity, the incidence of EBV-associated oral non-Hodgkin’s lymphoma, regardless of immune status, is comparable to non-Hodgkin’s lymphoma arising at other anatomical sites (Gulley et al., 1995, Hummel et al., 1995, Leong et al., 2001, Solomides et al., 2002). It is important to note that oral lymphomas are often misdiagnosed. Common manifestations of intraoral non-Hodgkin’s lymphoma include swelling and ulceration at various regions throughout the oral cavity (involving the tonsils, gingiva, tongue, palate, and buccal mucosa), tooth mobility, and pain (Ardekian et al., 1999, Richards et al., 2000). As the manifestation of oral lymphomas mimic symptoms of periodontal disease, osteomyelitis, or other diseases (Richards et al., 2000), misdiagnosis often delays initiation of proper treatment resulting in worsened disease outcome (Dodd et al., 1992, Nittayananta et al., 1998, Spatafore et al., 1989). Thus, understanding how EBV contributes to oral lymphomagenesis will be important in uncovering virally derived biomarkers for early diagnosis and treatment.
EBV and Oral Diffuse Large B-Cell Non-Hodgkin’s Lymphoma
EBV has been associated with DLBCL of the elderly, a clonal B cell lymphoma occurring more commonly in older patients (\> 50 years of age) from Asia (Reviewed in (Ok et al., 2013)). Though less frequently, these tumors can also occur in younger persons, as well as in North America or Europe. Determination of EBV status is based on in situ hybridization detection of the EBERs. The EBER transcripts are an abundantly expressed set of viral noncoding RNAs that are frequently used for the clinical detection of EBV. Assignment of EBV positivity is usually based on all tumor cells being positive for EBV. However, the percentage of EBER-positive cells varies in DLBCL. The incomplete association of EBER in DLCBL suggests that EBV in a few cells may be sufficient to support the oncogenic phenotype. EBV viral proteins and RNAs have been shown to be transferred in exosomal vesicles with phenotypic effects transferred to the uninfected cells (Meckes et al., 2013, Pegtel et al., 2011). Alternatively, EBERs may not be the most robust marker for EBV detection in theses tumors, and a stronger correlation with EBV infection may be missed. The EBV status in oral DLBCL is not well defined due to the rarity of these tumors. In general, EBV-positive DLBCL has been shown to carry a lower frequency of p53 mutations and increased macrophage infiltration in contrast to EBV-negative DLBCL (Courville et al., 2016, Morscio et al., 2017). EBV-positive DLBCL display a type II or III latency pattern. The oncogenic phenotype of EBV-positive DLBCL is thought to be regulated by the EBV oncoprotein LMP1, an integral membrane protein that promotes cell proliferation and survival. LMP1 signals in a ligand-independent manner and mimics CD40 signaling with activation of a number of signaling pathways that include NF-kB, JNK/AP-1, MAPK, and PI3K-Akt. A phenotype of DLBCL is activation of the NF-kB pathway, which is known to also be activated by LMP1. EBV-positive DLBCL carry a poorer prognosis than EBV-negative DLBCL.
EBV and Oral Burkitt’s Lymphoma
BL is a rapidly proliferating tumor that arises at extranodal sites in children and adults. The hallmark of BL is a chromosomal translocation involving MYC and the immunoglobulin gene locus, resulting in high levels of MYC expression (Zech et al., 1976). BL is categorized into three subtypes: endemic or African, sporadic, and AIDS-associated. These BL forms share clinical and histological presentation, but differ in geographical region and prevalence of EBV infection. Endemic BL occurring mainly in children in the equatorial belt of Africa is very highly associated with EBV infection, with a nearly 100% association, while sporadic BL and HIV-associated BL exhibit a lower prevalence of EBV-positivity at approximately 10–20% and 30–60%, respectively (Magrath, 1990, Mbulaiteye et al., 2014). Oral BL is more prominent in the endemic BL form where about half appear in the jaw, while most sporadic BL present as an abdominal mass (Silva et al., 2016).
EBV is thought to play an early role in the development of BL. Some BL tumors are a clonal expansion of a single EBV-infected cell (determined by the terminal repeat number as a marker of clonality), suggesting that infection occurred prior to proliferation and expansion of the tumor cells. High EBV titers are a risk factor for development of BL. In addition to EBV, malaria has been implicated as a co-factor in endemic BL. Parasite burden has been shown to correlate with the incidence of EBV-positive BL in geographic regions endemic for malaria (Morrow, 1985). It has been suggested that malaria-induced immunosuppression of T cells or T cell exhaustion allows for greater expansion of EBV-positive proliferating B cells, which in turn increases the probability of a MYC translocation event and subsequent BL formation (Ho et al., 1986, Whittle et al., 1984). Constitutive c-Myc expression drives B cell proliferation but also induces apoptosis through the p53 pathway or the BCL2-like protein 11 (BIM) apoptotic activator (Harrington et al., 1994). However, EBV-positive BL show resistance to apoptosis compared to EBV-negative BL suggesting that EBV confers protection from c-Myc-mediated apoptosis (Kelly et al., 2006, Piccaluga et al., 2015). Most EBV-positive BL display a latency I viral gene expression program, with EBNA1, LMP2A, and viral microRNAs detected (Rowe et al., 1987). These viral factors have been shown to provide survival advantages to B cells by various mechanisms (Kennedy et al., 2003, Lu et al., 2011, Riley et al., 2012).
Mapping of the mutation spectrum of BL has uncovered a number of mutations in addition to the defining MYC-immunoglobulin gene translocation. TP53 mutations occur in approximately 40% of BL tumors (Bhatia et al., 1992, Giulino-Roth et al., 2012). Other common mutations include the negative transcriptional regulator ID3 (in 34% of BL), anti-apoptotic gene MCL1 (in 17% of BL) and chromatin remodelers ARID1A and SMARCA4 (in 25% of BL) (Giulino-Roth et al., 2012, Love et al., 2012). Importantly, EBV-positive BL have a lower number of mutations than EBV-negative BL (Giulino-Roth et al., 2012, Vockerodt et al., 2008). In addition, DNA hypermethylation of the B-Lymphocyte-Induced Maturation Protein 1 promoter, involved in B cell terminal differentiation with putative tumor suppressor activity, is more frequent in EBV-positive BL than EBV-negative BL (Zhang et al., 2014). The observations support the notion that EBV may substitute the requirement for mutation during lymphomagenesis.
EBV and Oral Lymphomas in the Immunocompromised Host
Secondary immune suppression due to AIDS or transplantation carries an increased incidence for lymphoma. Prior to antiretroviral therapy, AIDS patients showed a 60 to 200-fold increase in lymphoma compared to HIV-negative individuals (Bower et al., 2006). Many of these lymphomas were linked to EBV (Carbone, 2003, Shibata et al., 1993). Plasmablastic lymphomas are an aggressive oral lymphoma that frequently occur in the jaw and oral mucosa of AIDS patients. Plasmablastic lymphoma is a variant DLBCL with immunoblastic morphology and plasma cell immunophenotype that is associated with latent EBV infection in approximately 70% of cases (Colomo et al., 2004, Delecluse et al., 1997, Gaidano et al., 2002). Introduction of antiretroviral therapies decreased the incidence of HIV-associated non-Hodgkin’s lymphomas (Hishima et al., 2006). In transplant patients, Post-Transplant Lymphoproliferative Disease (PTLD) is a life-threatening complication (Nalesnik et al., 1988). PTLD consists of a spectrum of disorders that range from a benign polyclonal lymphoid proliferation to a malignant/clonal lymphoma. PTLD mainly occurs in the gastrointestinal tract, and a few cases of oral PTLD have been reported (Amorim Pellicioli et al., 2016, Lones et al., 1995, Ojha et al., 2008). Intraoral PTLDs have been observed in the gingiva, hard palate, and tongue (Broudy & Sabath, 1995, Chang et al., 1994, Hanto et al., 1981, Johnson et al., 2007, Oda et al., 1996, Ojha et al., 2008, Raut et al., 2000). The risk of PTLD is dependent on the organ transplant, the age and EBV status of the patient, and type and duration of immune suppression, with PTLD incidence ranging from 1 to 20%. Latent EBV is associated with 80% of PTLD cases, predominating in early PTLD which appear within the first year following immune suppression. Furthermore, EBV-seronegative transplant recipients are 20 times more likely to develop PTLD (Haque et al., 1996). Thus, PTLD is associated with primary EBV infection where EBV latency III/growth program stimulates B cell growth that goes unchecked in the absence of immune control. Restoration of immune function through adoptive T cell therapy with EBV-specific cytotoxic T cells or reduction of immunosuppression results in regression of the tumor in many cases (Bollard et al., 2012).
Go to:
EBV and Oral Carcinoma
Given its tropism for epithelial cells and lifelong residence in the oral cavity, EBV has also been linked to carcinomas arising in the oral cavity. Although not an oral carcinoma per se, EBV association with NPC is well established and has provided correlates for EBV’s role in carcinoma. NPC is an aggressive, highly invasive squamous cell carcinoma with prominent lymphoid infiltrates that arises in the nasopharynx. NPC is prevalent in Southern China, Southeast Asia, and Inuit populations accounting for 20% of all cancers in these endemic regions, but NPC is rare in Western populations. NPC has been classified into 3 groups according to the differentiation state and keratinizing tumor morphology. Nearly all undifferentiated NPC are associated with EBV. Increased EBV antibody titers have been reported approximately three years prior to NPC detection (Ji et al., 2007). EBV infection has also been shown to follow early genetic changes in the premalignant epithelium to facilitate a stable latent infection. NPC tumors display a type II latent EBV infection which is defined by expression of viral oncogenes LMP1, LMP2, EBNA1, and viral noncoding RNAs. Importantly, EBV infection of epithelial cells has been shown to confer phenotypes observed in NPC tumors. EBV infection is able to delay differentiation, likely reprogramming epithelial cells with features of basal or progenitor stem cells (Birdwell et al., 2014). LMP2A has been shown to induce a delay in epithelial differentiation (Scholle et al., 2000), while LMP1 can induce a cancer stem cell/progenitor phenotype in nasopharyngeal epithelial cells (Kondo et al., 2011). In addition, EBV infection has been shown to confer a metastatic phenotype to EBV-infected cells (Queen et al., 2013, Kassis et al., 2002). Thus, EBV infection in the context of carcinoma may promote tumor progression conferring the salient phenotypes that are associated with the morbidity and mortality of NPC.
EBV and Oropharyngeal Squamous Cell Carcinoma
Epidemiological studies have revealed variable rates of EBV infection in OSCC, ranging from no association to 100%. Geographic and ethnic differences are one explanation for the varied EBV association in OSCC. (Bagan et al., 2008, Cruz et al., 1997, D’Costa et al., 1998, Iamaroon et al., 2004, Kobayashi et al., 1999, Sand et al., 2002, Tsang et al., 2003). However, inconsistencies in detection methods and the prevalence of EBV in the oral cavity, in particular EBV-positive lymphoid tumor infiltrates, have obscured the ability to definitively associate EBV with OSCC. In addition, epithelial tissues exhibiting severe dysplasia show a more pronounced EBER expression than OSCC, suggesting that EBERs may not be a reliable marker for assigning EBV-positivity in OSCC (Kikuchi et al., 2016). In addition to EBER, LMP1 and EBNA2 have been detected in OSCC (Kikuchi et al., 2016, Shimakage et al., 2002). LMP1 in particular has been detected in the absence of EBER expression, consistent with the possibility of an EBER-negative latent EBV infection in OSCC (Gonzalez-Moles et al., 2002, Bonnet et al., 1999, Kobayashi et al., 1999, Sugawara et al., 1999). Fewer than one EBV genome per cell has been detected in OSCC, further raising the question of whether EBV serves as a factor in tumor progression or is simply a passenger (Goldenberg et al., 2004). However, several studies have demonstrated considerably higher levels of EBV infection in OSCC versus healthy tissues of the same cohort (Bagan et al., 2008, Cruz et al., 1997, D’Costa et al., 1998, Jiang et al., 2015, Kobayashi et al., 1999, Sand et al., 2002).
An epidemic rise in OSCC has been observed over the past several decades that is associated with human papillomavirus, specifically HPV16 (Ramqvist & Dalianis, 2010). HPV is a small DNA tumor virus more traditionally associated with cancers arising in the anogenital tract. EBV and HPV co-infection have been detected in 15–20% of carcinomas occurring in the oropharynx (Jalouli et al., 2012, Polz-Gruszka et al., 2015). Interestingly, the vast majority of OSCC occurs in the tonsils and the base of tongue, lymphoid-rich regions where EBV resides (Dahlstrand & Dalianis, 2005, Licitra et al., 2002). Specific analysis of EBV/HPV co-infection in tonsillar and base of tongue squamous cell carcinoma has shown co-infection rates of 25% and 70%, respectively (Jiang et al., 2015). This study also showed that all tumors harbored integrated HPV, suggesting that when EBV was detected it was likely in a cell harboring an integrated HPV (Jiang et al., 2015). OSCC prognosis has been shown to vary depending on a number of factors, particularly age, with older patients exhibiting poorer prognosis (Jadhav & Gupta, 2013). However, HPV-positive OSCC exhibit a better prognosis compared to HPV-negative OSCC with treatment de-escalation being recommended to reduce the extensive morbidity following chemotherapy (Benson et al., 2014). A better understanding of the etiology of HPV-positive OSCC is critical for the development of effective treatment regimens.
HPV-positive OSCC exhibits distinct characteristics when compared to other HPV-associated cancers. HPV-positive OSCC are poorly differentiated, highly invasive, and exhibit a more rapid onset, developing within a matter of years as opposed to decades. A correlation between EBV infection and poor differentiation status in OSCC has been demonstrated (Gonzalez-Moles et al., 1998). Experimentally, EBV infection has been shown to delay epithelial differentiation and promote an invasive phenotype, further enhancing the invasiveness of epithelial cells expressing HPV16 E6 and E7 oncogenes (Birdwell et al., 2014, Jiang et al., 2015, Kassis et al., 2002, Queen et al., 2013). Furthermore, delayed differentiation and enhanced invasiveness were retained in epithelial cells even after loss of EBV, indicating that a stable epigenetic reprogramming followed EBV infection (Birdwell et al., 2014, Queen et al., 2013). EBV could therefore contribute to OSCC pathogenesis via epigenetic reprogramming of infected tumor cells, and help explain the inconsistent detection of EBV in OSCC. How EBV might contribute to the pathogenesis of HPV-positive OSCC still needs to be defined, but may reflect the influence of HPV and EBV on one another’s viral lifecycles. One study showed that EBV/HPV co-infection increased both EBV and HPV replication in organotypic raft culture (Makielski et al., 2016). Alternatively, HPV infection may alter the EBV life cycle to favor latency, which was observed when EBV infected HPV-immortalized organotypic raft cultures (Guidry and Scott, unpublished observations). In either case, increased viral outputs or latency are consistent with clinical manifestations of EBV-associated carcinomas.
EBV and Salivary Gland Epithelioma
EBV infection is also linked to salivary gland epithelioma, a rare carcinoma endemic to southern Chinese and Arctic Inuit populations (Albeck et al., 1993, Kuo & Hsueh, 1997, Leung et al., 1995). salivary gland epithelioma exhibits histological similarities of non-keratinizing, undifferentiated NPC and most commonly occurs in the parotid gland with lymphoid infiltrates (Ambrosio et al., 2013). Endemic areas have a salivary gland epithelioma incidence of 5.9% (Abdulla & Mian, 1996), with an almost complete association with EBV infection (Abdulla & Mian, 1996, Iezzoni et al., 1995, Jen et al., 2003). EBV in salivary gland epithelioma has been characterized as a clonal latent EBV infection (Leung et al., 1995) specifically detected in carcinoma cells and not in infiltrating lymphocytes or in surrounding benign tissues (Hamilton-Dutoit et al., 1991, Huang et al., 1988, Iezzoni et al., 1995, Jen et al., 2003, Lanier et al., 1991). LMP1 protein has been detected in a subset of EBV-positive salivary gland epithelioma (Jen et al., 2003, Leung et al., 1995), in which a considerable portion of tumors exhibited C-terminal mutations in LMP1, including a 30bp C-terminal deletion characteristic of EBV-associated NPC in Chinese populations, as well as various C-terminal point mutations. The C-terminal deletion/mutations are thought to promote cellular proliferation, and may enhance the oncogenic effects of EBV in salivary gland epithelioma (Jen et al., 2003).
EBV and Oral Hairy Leukoplakia
Particularly seen in AIDS patients, OHL is another disease manifestation in the oral epithelium associated with EBV infection (Braz-Silva et al., 2008, Mabruk et al., 1994, Mabruk et al., 1996, Schmidt-Westhausen et al., 1993). OHL itself is not necessarily associated with significant morbidity or mortality, but instead serves as sign of immunodeficiency, particularly in the context of HIV infection (Chattopadhyay et al., 2005, Cherry-Peppers et al., 2003, Greenspan et al., 2004). OHL presents as elevated white lesions typically at the lateral borders and dorsum of the tongue, though lesions have also been described at the soft palate, floor of mouth, and buccal and oral mucosa (Triantos et al., 1997). OHL directly results from EBV replication, and is not related to a latent EBV infection (Greenspan et al., 1985, Greenspan & Greenspan, 1989, Walling, 2000). Treatment with the herpesvirus antiviral nucleoside analog acyclovir, which inhibits EBV replication, was shown to resolve OHL lesions within a matter of weeks (Resnick et al., 1988). Antiretroviral therapies and reconstitution of immune function have reduced OHL in HIV-infected individuals.
The presence of permissive EBV replication makes OHL unique compared to EBV-associated malignancies; however, latency-associated genes are also concomitantly expressed in OHL (Sandvej et al., 1992, Thomas et al., 1991, Webster-Cyriaque & Raab-Traub, 1998, Webster-Cyriaque et al., 2000), which may influence regulation of cell proliferation and apoptosis and likely contribute to its histopathologic features (Walling, 2000). EBV replication in OHL does not culminate in cell lysis, likely due to the expression of anti-apoptotic viral genes, such as LMP1, which induces anti-apoptotic cellular gene expression, and BHRF1, which acts as a viral Bcl-2 homologue (Henderson et al., 1993). EBV oncogenic gene expression and the consequential cell survival in the face of extensive viral replication likely contribute to acanthosis, a hypertrophy of the infected epithelium at the spinous layer with EBV replication itself contributing to the koilocytic changes characteristic of OHL (Becker et al., 1991, Dawson et al., 1995, Triantos et al., 1997, Webster-Cyriaque & Raab-Traub, 1998). OHL may also exhibit a heterogeneous EBV infection characterized by co-infection of different EBV types and strain variants (Walling et al., 1992, Walling et al., 1994, Walling et al., 1995, Walling et al., 1999, Walling & Raab-Traub, 1994). Similar heterogeneous EBV infections have also been detected in immunocompetent individuals and could potentially enhance EBV pathogenicity in OHL (Burrows et al., 1996, Gan et al., 2002, Kelly et al., 2002, Midgley et al., 2000, Walling, 2000).
Go to:
Summary
Although the oral cavity serves as the site of EBV residence and transmission, EBV-associated oral cancers are relatively rare, but are often misdiagnosed as symptoms mimic those of less severe diseases. In general, EBV-associated cancers do not seem to predominate in the oral cavity, but the oral cavity likely serves as a primary site of persistence that seeds cancers at other sites such as the nasopharynx and stomach. The role of EBV in its associated cancers is co-factorial requiring other genetic alterations and is associated with other infections (malaria and HPV). However, EBV infection is a critical oncogenic event that correlates with a rapid tumor progression and metastatic phenotype. Standard techniques for EBV detection are not always reliable as EBV gene expression may vary in different settings. Incomplete viral associations are often reported, but may reflect bystander oncogenic effects of EBV in the microenvironment or loss of EBV during tumor evolution. EBV-induced epigenetic reprogramming provides a mechanism for viral “hit-and-run” where maintenance of oncogenic phenotypes occurs in the absence of the virus or viral gene expression. Thus, additional studies will continue to define the contributions of EBV to oral tumor initiation and progression and provide virus-associated biomarkers for diagnosis, prognosis, and treatment.